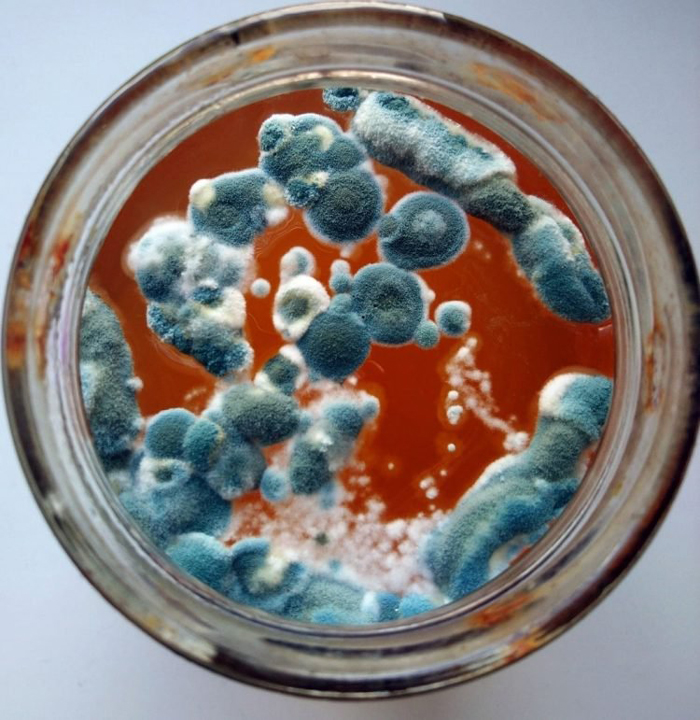

کمی هم زیبایی های کپک را ببینیم!
از نظر یک گروه آنلاین در روسیه، قارچ که معمولا با مرگ و فساد مرتبط است، واقعا زیباست و برای اثبات حرفشان عکس هم دارند.

احتمالا «زیبایی» کلمهای نیست که بیشتر ما برای توصیف کپک استفاده میکنیم، اما از نظر یک گروه آنلاین در روسیه، قارچ که معمولا با مرگ و فساد مرتبط است، واقعا زیباست و برای اثبات حرفشان عکس هم دارند. در واقع گروهی از علاقمندان کپک دور هم جمع شده و تصاویری از زیباییهای آن را در اینترنت به اشتراک میگذارند.
این گروه در سال ۲۰۱۵ در یک شبکه اجتماعی روسی به وجود آمده و اکنون بیش از ۵۰ هزار عضو دارد که بسیاری از آنها دائما تصاویر جالبی از کپک را پُست میکنند که در خانه هایشان پرورش داده اند. برخی از آنها واقعا جذاب هستند. اگر از چندش آور بودن بتوانید نادیده بگیرید، زیبایی کپک را درک خواهید کرد.
بنیانگذاران این گروه میگویند: «برای دیدن زیبایی باید از یک خط عبور کنیم، جایی که تنفر به پایان میرسد و تحسین آغاز میشود. طبیعت زیباست، اما نباید برای کشف آن عجله کنید، باید آرام بنشینید، نگاه کنید و بررسی کنید.»
منبع: برترین ها

1980





















